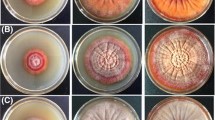

Abstract
The effect of different doses of visible (Vis), ultraviolet-А (UVA), and mixed light (UVA + Vis) upon coenzyme Q10 (CoQ10) and β-carotene synthesis and biomass yield by the Sporobolomyces salmonicolor AL1, Cryptococcus albidus AS55, Cryptococcus laurentii AS56, and C. laurentii AS58 strains isolated from Antarctic samples was investigated. The β-carotene concentration in the red strain biomass increased by 52% under irradiation with 11 J/cm2 Vis, and the CoQ10 concentration rose by 37% in relation to the control quantity obtained through dark cultivation. Under irradiation with 6 J/cm2 UVA, the S. salmonicolor AL1 strain synthesized 15% more β-carotene; C. albidus AS55, 22%; C. laurentii AS56, 44%; and C. laurentii AS58, 35% in relation to the control quantity. Irradiation with a low UVА + Vis dose significantly stimulated β-carotene biosynthesis by the strains of the Cryptococcus genus (87%, 138%, and 100%), whereas S. salmonicolor AL1 increased the β-carotene content to a smaller degree (55%). Higher doses of all three irradiation types inhibited β-carotene accumulation. Vis suppressed CoQ10 biosynthesis in the Cryptococcus strains, whereas UVА and UVА + Vis inhibited it in all four strains. The S. salmonicolor AL1 strain pre-treated with 0.02 J/cm2 UVA synthesized twice as much CoQ10 and β-carotene when cultivated in the presence of Vis light in an 11-J/cm2 dose.
Similar content being viewed by others
Explore related subjects
Discover the latest articles, news and stories from top researchers in related subjects.Avoid common mistakes on your manuscript.
Introduction
Yeasts isolated from Antarctic [1] and freshwater ecosystems [2] have become the focus of attention for researchers who study the biosynthesis of photoprotective substances as a barrier against ultraviolet radiation (UV). UV has wavelength in the range of 200–400 nm and visible radiation (Vis) from 400 to 800 nm. In recent years, UV reaching the earth due to the reduction of the ozone layer has been noticed in terms of potential health hazard on humans, animals, and environment. High UV exposure causes damages to DNA, proteins, including cell membrane lipoproteins and organelles [3].
Terrestrial microorganisms in habitats exposed to high UV produce different pigments potentially protecting against UVB damages. UV-screening compounds provide a passive method for the reduction of UV-induced damage, and they are widely distributed across the microbial, plant, and animal kingdoms [4]. The synthesis of carotenoids that quench oxygen-free radicals generated by UV-induced photochemical reactions [5] is also an important response in preventing UV-induced damage to a wide diversity of biological macromolecules.
Carotenoids are important natural pigments that are found widely distributed in plants and microorganisms. Animals depend on vegetation for carotenoids because they cannot synthesize these pigments de novo. Carotenoids play an essential role as accessory light-harvesting pigments and, especially, in protection against damage by photosensitized oxidation [6]. Dietary studies have shown that β-carotene is useful in combating various types of cancers and other diseases owing to its antioxidant and provitamin-A potential [7, 8]. Several yeast genera—Rhodotorula, Sporobolomyces, Rhodosporidium, and Cryptococcus—produce β-carotene, torulene, torularhodin, which also belong to the carotenoid group, and coenzyme Q10 (CoQ10) [9–11]. CoQ10 has a similar isoprenoid chain in its structure. It is also an interesting product for biotechnology. CoQ10 is present in all cells and membranes, and in addition to being a member of the mitochondrial respiratory chain, it also has several other functions of great importance for the cellular metabolism, such as participation in the extra-mitochondrial electron transport (plasma membranes and lysosomes), regulation of the mitochondrial permeability of transition pores, and regulation of the physicochemical properties of membranes [12]. CoQ10, especially, is widely used as an essential component of ATP generation in the oxidative phosphorylation process and as an antioxidant preventing lipid peroxidation and scavenging superoxide. It has been proved that the CoQ10 yeast is much better absorbed by the skin than the synthetic CoQ10. Peroxide reduction in the stratus corneum is considerably more pronounced after yeast CoQ10 application [13]. Therefore, research efforts on the production of CoQ10 by microorganisms focus on the development of potent strains by conventional mutagenesis and metabolic engineering, analysis and modification of the key metabolic pathways, and optimization of fermentation strategies [14]. Various microorganisms, including bacteria (e.g., Agrobacterium, Rhodobacter, and Paracoccus) and yeasts (e.g., Candida, Rhodotorula, and Saitoella), are reported as CoQ10 producers in patented laid-open applications [15] purposely applied in pharmaceutical and cosmetic industry.
The aim of the present study was to examine the effect of ultraviolet-A radiation, Vis light, and a combination of both on СоQ10 and β-carotene biosynthesis by the Sporobolomyces and Cryptococcus genera isolated from Antarctic samples.
Materials and Methods
Microorganisms
The four strains included in this study were isolated from soil and lichen from Livingston Island, Antarctica. Sporobolomyces salmonicolor AL1 NBIMCC 8290 has been preserved in the National Bank for Industrial Microorganisms and Cell Cultures. Cryptococcus albidus AS55, Cryptococcus laurentii AS56, and C. laurentii AS58 were identified according to the yeast classification criteria proposed by Kurtzman and Fell in 1998 in a previous investigation [16].
Media and Growth Conditions
The fermentation medium contained (g/l) sucrose, 30; (NH4)2SO4, 1.0; KH2PO4, 0.5; MgSO4·7H2O, 0.5; NaCl, 0.01; CaCl2·2H2O, 0.1; and yeast extract, 1.0. The initial pH was adjusted to 5.3, and the medium was sterilized at 112 °C for 30 min. The inoculum was obtained on a rotary shaker (220 rev/min) in 500 ml Erlenmeyer flasks containing 50 ml of Sabouraud medium (Merck, Germany) on a shaker at 24 °C, 48 h. The fermentation medium was inoculated with 10% (w/v) of inoculum. The cultivation was carried out in 500 ml Erlenmeyer flasks containing 50 ml of the fermentation medium on a rotary shaker (220 rev/min) at 22 °C for 96 h. The biomass was separated by centrifugation (6,000 g, 30 min), washed twice with distilled water, and lyophilized.
Treatment with Light
The CoQ10 and β-carotene synthesis was carried out under deep cultivation in the dark, in Vis, under ultraviolet-А (UVA), and mixed (UVA + Vis) irradiation with different doses. The β-carotene, CoQ10, and biomass quantities obtained during dark cultivation of the strains were accepted as control quantities.
An F15T8/DALTO Daylight Full Spectrum Fluorescent (Sylvania Danvers, MA, USA) lamp and two F15T8/BLB lamps with emission range from 345 to 400 nm, peak 365 nm (Sylvania Danvers, MA), placed at 20 cm above the culture medium were used as irradiation sources. Working periods of 3 or 12 h ensured the respective irradiation doses. Total irradiance was measured using an Almemo2690-8 data logger with the respective sensors: radiation measuring head Type FLA613VLM with spectral sensitivity from 360 to 760 nm and UV400 filter, and UVA radiation probe head Type FLA613UVA with spectral sensitivity from 310 to 400 nm in mW/cm2, all from Ahlborn (Germany).
Four experiments were carried out using differing irradiation treatment. In the first experiment, the strains were cultivated under irradiation with 11, 24, 58, 69, and 97 J/cm2 Vis. In the second experiment, the cultures developed under irradiation with 6, 12, 24, 45, and 52 J/cm2 UVA doses. The fermentations in the third experiment were carried out under irradiation with 3 + 16, 5 + 25, and 6 + 32 J/cm2 doses of UVA + Vis, respectively. In the fourth experiment, the S. salmonicolor AL1 strain was pre-treated with 0.02, 0.08, 0.15, 0.30, 0.45, and 0.90 J/cm2 UVA doses, then each of the treated variants was deep cultivated in two ways: in the dark and under irradiation with an 11-J/cm2 dose of Vis.
Extraction and Analysis of CoQ10 and β-carotene
The extraction procedure for CoQ10 and β-carotene was adapted from Gimeno et al. [17]. Twenty milligrams of dry biomass was finely ground and transferred into a dark polypropylene tube (Herolab, Germany); 2 ml acetone was added, and it was vortexed for 2 min and centrifuged for 5 min at 3,000 g (Hettich EBA 20, Germany). The extraction procedure was repeated. The combined extracts were evaporated dry on a rotary vacuum evaporator (Вüchi, Swetzerland) fitted with high vacuum pump E2M-1 (Edwards, England). The dry residue was dissolved in 1 ml mobile phase A, then filtered through a 0.20-μm syringe filter (Acrodisc, Germany), and 20 μl of the filtrate was injected for analysis. All sample preparation stages were carried out quickly and in dim light.
The high-performance liquid chromatography (HPLC) system was composed of a ProStar 230 solvent delivery module and photo diode array detector model 335, Microsorb-MV C18 column (150 × 4,6 mm, 5 μm particle size), all from Varian (Australia). A solvent system including methanol, n-hexane, 2-propanol in proportions 70:25:5 v/v (a), and acetonitrile (b) was used in gradient condition from 30А:70В tо 90А:10В. The flow rate was 1 ml/min and detection at 450 nm for β-carotene and 270 nm for CoQ10, respectively. All HPLC-grade solvents were obtained from Labscan (Ireland).
The compounds of interest were identified according to their retention times determined using authentic CoQ10 and β-carotene standards (Sigma, USA). They were quantified using an absolute calibration curve. Star Chromatography Workstation Version 6.30 (build 5) software was used.
Statistical Analysis
The data were analyzed using the Statistical Package for the Social Sciences for Windows software, Version 11.0. Statistically significant differences between groups were determined by analysis of variance. When the differences were significant, Duncan's multiple range test was performed. Means were considered significantly different at p < 0.05.
Results and Discussion
The effect of different Vis doses upon β-carotene and CoQ10 synthesis and biomass yield by S. salmonicolor AL1, C. albidus AS55, C. laurentii AS56, and C. laurentii AS58 strains was investigated. The results have been shown in Fig. 1.
Under dark cultivation conditions, β-carotene was synthesized in the following quantities: 63.8 μg/g by S. salmonicolor AL1, 23.2 μg/g by C. albidus AS55, 23.3 μg/g by C. laurentii AS56, and 25.5 μg/g by C. laurentii AS58. Maximum β-carotene concentration in the red strain biomass was reached at a dose of 11 J/cm2 Vis making up 52% increase in relation to the control. The Cryptococcus strain exhibited insignificant increase at 24 J/cm2 Vis. The β-carotene quantities decreased considerably in all strains with the increase in the irradiation doses up to 97 J/cm2 Vis.
The CoQ10 control quantities varied within a narrow range: 201.6 μg/g for S. salmonicolor AL1, 210.6 μg/g for C. albidus AS55, 190.8 μg/g for C. laurentii AS56, and 197.6 μg/g for C. laurentii AS58. Culture reaction differed under the influence of different Vis doses. The CoQ10 concentration in the S. salmonicolor AL1 biomass rose by 37% in relation to the control quantity under treatment with an 11-J/cm2 dose and decreased with the increase in the irradiation dose. Vis irradiation suppressed CoQ10 synthesis by the Cryptococcus strains leading to a concentration lower than the control quantity. The strains studied, especially those of the Cryptococcus genus, exhibited a high biomass yield at an 11-J/cm2 Vis irradiation dose. The yield decreased with the increase in doses.
The results shown in Fig. 2 demonstrate that UVА in a 6-J/cm2 dose was favorable to β-carotene formation in Antarctic yeast, while with the increase in irradiation doses to 52 J/cm2, its content was significantly reduced. At a lower irradiation dose, S. salmonicolor AL1 synthesized 15% more β-carotene in comparison with the control quantity, whereas the strains of the Cryptococcus genus increased the carotenoid content by 22%, 44%, and 35% for C. albidus AS55, C. laurentii AS56, and C. laurentii AS58, respectively. UVА inhibited CoQ10 biosynthesis and suppressed yeast development, higher doses leading to reduced quantities of synthesized biomass.
The results of the experiment involving irradiation of Antarctic yeast with mixed light (UVА + Vis) have been shown in Fig. 3. Mixed light stimulated β-carotene biosynthesis in psychrophilic yeast. The C. albidus AS55, C. laurentii AS56, and C. laurentii AS58 strains, where β-carotene levels are constitutionally low (23–25 μg/g), increased its concentration considerably by 87%, 138%, and 100% in relation to the control quantity when irradiated with a dose of 3 + 16 J/cm2 (UVА + Vis). The S. salmonicolor AL1 strain with constitutionally 2.5 times more β-carotene in comparison to the strains of the Cryptococcus genus showed a smaller increase in its content (55%) under the effect of mixed irradiation. After irradiation with the two doses 3 + 16 J/cm2 (UVА + Vis) and 5 + 25 J/cm2 (UVА + Vis), the CoQ10 content increased slightly in the biomass of S. salmonicolor AL1 only.
Irradiation with a 3 + 16-J/cm2 (UVA + Vis) dose stimulated biomass accumulation in all strains. The highest yield was obtained by the S. salmonicolor AL1 strain: 26.4% in relation to the control quantity, followed by C. laurentii AS56 with 9.7%. When the irradiation dose was increased to 5 + 25 J/cm2 (UVA + Vis) and 6 + 32 J/cm2 (UVА + Vis), S. salmonicolor AL1 kept developing, whereas the same doses inhibited the strains of the Cryptococcus genus.
The next experiment was conducted with a S. salmonicolor AL1 strain pre-treated with different UVA doses and deep cultivated in the dark and in the light, at a dose of 11 J/cm2 Vis. The results have been shown in Fig. 4.
The preobtained dose of 0.02 J/cm2 UVA was a positive factor in β-carotene and CoQ10 induction during the subsequent strain cultivation both in the dark and in the presence of light. The β-carotene and CoQ10 quantity was twice as large (63.8–132.9 and 201.6–430.9 μg/g, respectively) under light cultivation and over 1.5 times as large (63.8–103.5 and 201.6–325.4 μg/g, respectively) under dark cultivation. With the rise in the UVA irradiation dose, the values of the β-carotene and biomass indices decreased, whereas the CoQ10 level increased even at a dose of 0.45 J/cm2.
Our study proved the ability of psychrophilic yeast of the Sporobolomyces and Cryptococcus genera isolated from Antarctic samples to synthesize β-carotene and CoQ10 when irradiated with Vis, UVA, and mixed light. The biomass quantities accumulated by S. salmonicolor AL1, C. laurentii AL58, C. albidus AL55, and C. laurentii AL56 were larger under irradiation with low Vis doses than those accumulated under dark cultivation. White light stimulated β-carotene and CoQ10 biosynthesis in pigment-forming S. salmonicolor AL1 strain, while the β-carotene quantity in the strains of the Cryptococcus genus was not affected by the cultivation conditions. Studying the effect of light on carotenogenesis in six strains of Phaffia rhodozyma, Vazquez proved they all produced greater amounts of total carotenoids in the light than in the dark, and the illumination influenced not only total carotenoid concentrations but also the carotenoid profile, biomass, and xylitol concentrations [18]. A research on the effect of weak white light on the growth and carotenogenesis of Rhodotorula glutinis showed that red strain growth was slightly inhibited, but the biosynthesis of carotenoids, torularodin in particular, was stimulated [19]. Carotenoid production and accumulation are reported to be positively affected by white-light irradiation in algae, fungi, and bacteria. However, the intensity and protocol of illumination varies with the microorganism [20].
Antarctic yeasts, in particular, the highly pigmented species, were essentially resistant to UVА radiation, at least up to 0.5 J/cm2, whereas less than 5% can survive a similar dose of UVB. It has been suggested that resistance may be associated with pigmentation, possibly carotenoids and related pigments, that may afford important protection [1]. In our experiments, UVA radiation stimulated β-carotene biosynthesis in small doses only and suppressed CoQ10 accumulation. The rise in β-carotene in the Cryptococcus strains was more pronounced compared to S. salmonicolor AL1, which demonstrated the defense reaction of Antarctic yeasts against UVA irradiation and was consistent with Libkind's conclusions [2].
The same tendency was observed with the biosynthesis of the investigated substances under the effect of mixed light. The β-carotene quantity in the biomass of C. laurentii AS56 and C. laurentii AS58 at a dose of 3 + 16 J/cm2 (UVA + Vis) exceeded the controls by 100%. Carotenoid synthesis was clearly stimulated in six red yeast strains out of the 12 strains studied for their ability to produce photoprotective compounds—carotenoids and mycosporines—upon exposure to Vis or UV + Vis [21].
The highest CoQ10 and β-carotene quantities were obtained during the preliminary irradiation of the S. salmonicolor AL1 strain with UVА, and the subsequent deep cultivation at a dose of 11 J/cm2 Vis (430.9 μg/g) and in the dark (325.4 μg/g). These results can be interpreted in the light of the UVА effect on DNA expressed mainly as a change in pyrimidine bases [22] and activation of the photolyase enzyme under the effect of Vis. DNA photolyase is a flavoprotein that uses Vis light energy to split UV-induced cyclobutane pyrimidine dimers in damaged DNA [23].
The biomass quantity decreased with all yeast strains studied when they were subjected to UVA radiation. This effect was also observed by Tosi et al. during experiments with Antarctic soil fungi assemblages. They showed better growth when protected against UV radiation [24].
Conclusions
The investigations discussed and their results led to the conclusion that irradiation up to certain UVA and Vis doses stimulated СоQ10 and β-carotene biosynthesis by Antarctic yeast, whereas even low doses of UVA hindered the development of the four strains. This is the first report of CoQ10 presence in the biomass of the S. salmonicolor AL1 and the first investigations of the effect of UVA and Vis irradiation upon its biosynthesis.
The presence of СоQ10 and β-carotene in the biomass of the S. salmonicolor AL1 strain and the evidence of the stimulating UVA and Vis effect on their synthesis revealed some possibilities of their isolation and study with a view to their application to medicine, cosmetics, and agriculture.
References
Tsimako, M., Guffogg, S., Thomas-Hall, S., & Watson, K. (2002). Resistance to UVB radiation in Antarctic yeasts. Redox Report, 7, 312–314.
Libkind, D., Pérez, P., Sommaruga, R., Diéguez, M., Ferraro, M., Brizzio, S., et al. (2004). Constitutive and UV-inducible synthesis of photoprotective compounds (carotenoids and mycosporines) by freshwater yeasts. Photochemical & Photobiological Sciences, 3, 281–286.
Karentz, D. (1994). Ultraviolet tolerance mechanisms in Antarctic marine organisms. In C. Weler & P. Penhale (Eds.), UV radiation in Antarctica: Measurement and biological effects (pp. 92–110). Washington: American Geogphysical Union.
Cockell, C., & Knowland, J. (1999). Ultraviolet radiation screening compounds. Biological Review, 74, 311–345.
Krinsky, N. (1979). Carotenoid protection against oxidation. Pure and Applied Chemistry, 51, 649–660.
Phander, H. (1992). Carotenoids: an overview. Methods in Enzymology, 213, 3–13.
Edge, R., McGarvey, D., & Truscott, T. (1997). The carotenoids as anti-oxidants—a review. Journal of Photochemistry and Photobiology B: Biology, 41, 189–200.
Rock, C. (1997). Carotenoids: biology and treatment. Pharmacology and Therapeutics, 75, 185–197.
Bhosale, P., & Gadre, R. (2001). Production of β-carotene by a mutant of Rhodotorula glutinis. Applied Microbiology and Biotechnology, 55, 423–427.
Buzzini, P., & Martini, A. (1999). Production of carotenoids by strains of Rhodotorula glutinis cultured in raw materials of agro-industrial origin. Bioresource Technology, 71, 41–44.
Yurkov, M., Vustin, M., Tyaglov, B., Maksimova, I., & Sineokiy, S. (2008). Pigmented basidiomycetous yeasts are a promising source of carotenoids and ubiquinone Q10. Microbiology, 77, 1–6.
Turunen, M., Olsson, J., & Dallner, G. (2004). Metabolism and function of coenzyme Q. Biochimica et Biophysica Acta, 1660, 171–199.
Vinson, J., & Anamandla, S. (2005). Comparative topical absorption and antioxidant effectiveness of two forms of Coenzyme Q10 after a single dose and after long-term supplementation in the skin of young and middle-aged subjects. IFSCC Magazine, 8, 287–292.
Choi, J., Ryu, Y., & Seo, J. (2005). Biotechnological production and applications of coenzyme Q10. Applied Microbiology and Biotechnology, 68, 9–15.
Jap Pat (2003). No WO 056024.
Dimitrova, S., Pavlova, K., Lukanov, L., & Savova, I. (2008). Chemical composition of lipids and other lipophilic compounds from Antarctic yeast strains. Comptes Rendus de l'Academie Bulgare des Sciences, 61, 481–486.
Gimeno, E., Castellote, A., Lamuela-Raventós, R., de la Torre-Boronat, M., & López-Sabater, M. (2001). Rapid high-performance liquid chromatographic method for the simultaneous determination of retinol, α-tocopherol and β-carotene in human plasma and low-density lipoproteins. Journal of Chromatography B, 758, 315–322.
Vazquez, М. (2001). Effect of the light on carotenoid profiles of Xanthophyllomyces dendrorhous strains (formerly Phaffia rhodozyma). Food Technology and Biotechnology, 39, 23–128.
Sakaki, H., Nakanishi, T., Tada, A., Miki, W., & Komemushi, S. (2001). Activation of torularhodin production by Rhodotormla glutinis using weak white light irradiation. Journal of Bioscience and Bioengineering, 92, 294–297.
Bhosale, P. (2004). Environmental and cultural stimulants in the production of carotenoids from microorganisms. Applied Microbiology and Biotechnology, 63, 351–361.
Libkind, D., Diéguez, M., Moline, M., Perez, P., Zagarese, H., & van Broock, M. (2006). Symposium-in-print: UV effects on aquatic and coastal ecosystems occurrence of photoprotective compounds in yeasts from freshwater ecosystems of Northwestern Patagonia (Argentina). Photochemistry and Photobiology, 82, 972–980.
Schlegel, H. G. (1985). Allgemeine Mikrobiologie. Stuttgart: Georg Thieme Verlag.
Kao, Y., Saxena, C., Wang, L., Sancar, A., & Zhong, D. (2007). Femtochemistry in enzyme catalysis: DNA photolyase. Cell Biochemistry and Biophysics, 48, 32–44.
Tosi, S., Onofri, S., Brusoni, M., Zucconi, L., & Vishniac, H. (2005). Response of Antarctic soil fungi assemblages to experimental warming and reduction of UV radiation. Polar Biology, 28, 470–482.
Acknowledgements
The study was supported by Grant B-1615 from the National Fund Scientific Investigation.
Author information
Authors and Affiliations
Corresponding author
Rights and permissions
About this article
Cite this article
Dimitrova, S., Pavlova, K., Lukanov, L. et al. Synthesis of Coenzyme Q10 and β-carotene by Yeasts Isolated from Antarctic Soil and Lichen in Response to Ultraviolet and Visible Radiations. Appl Biochem Biotechnol 162, 795–804 (2010). https://doi.org/10.1007/s12010-009-8845-z
Received:
Accepted:
Published:
Issue Date:
DOI: https://doi.org/10.1007/s12010-009-8845-z